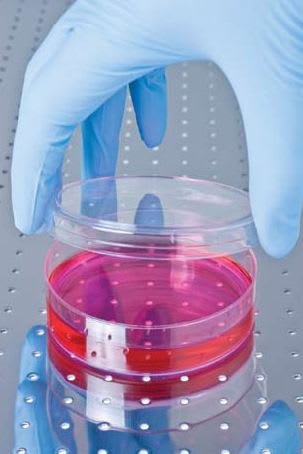

NASA Technology
It was an unlikely moment for inspiration. Engineers David Wolf and Ray Schwarz stopped by their lab around midday. Wolf, of Johnson Space Center, and Schwarz, with NASA contractor Krug Life Sciences (now Wyle Laboratories Inc.), were part of a team tasked with developing a unique technology with the potential to enhance medical research. But that wasn’t the focus at the moment: The pair was rounding up colleagues interested in grabbing some lunch.
One of the lab’s other Krug engineers, Tinh Trinh, was doing something that made Wolf forget about food. Trinh was toying with an electric drill. He had stuck the barrel of a syringe on the bit; it spun with a high-pitched whirr when he squeezed the drill’s trigger.
At the time, a multidisciplinary team of engineers and biologists—including Wolf, Schwarz, Trinh, and project manager Charles D. Anderson, who formerly led the recovery of the Apollo capsules after splashdown and now worked for Krug—was pursuing the development of a technology called a bioreactor, a cylindrical device used to culture human cells. The team’s immediate goal was to grow human kidney cells to produce erythropoietin, a hormone that regulates red blood cell production and can be used to treat anemia. But there was a major barrier to the technology’s success: Moving the liquid growth media to keep it from stagnating resulted in turbulent conditions that damaged the delicate cells, causing them to quickly die.
The team was looking forward to testing the bioreactor in space, hoping the device would perform more effectively in microgravity. But on January 28, 1986, the Space Shuttle Challenger broke apart shortly after launch, killing its seven crewmembers. The subsequent grounding of the shuttle fleet had left researchers with no access to space, and thus no way to study the effects of microgravity on human cells.
As Wolf looked from Trinh’s syringe-capped drill to where the bioreactor sat on a workbench, he suddenly saw a possible solution to both problems.
“It dawned on me that rotating the wall of the reactor would solve one of our fundamental fluid mechanical problems, specifically by removing the velocity gradient of the tissue culture fluid media near the reactor’s walls,” says Wolf. “It looked as though it would allow us to suspend the growing cells within the reactor without introducing turbulent fluid mechanical conditions.”
The three engineers skipped lunch. They quickly built a prototype from components lying around the lab and tested the bioreactor that night using hamster kidney cells (cheaper than their human counterparts). When the team returned in the morning, not much had changed; the cells were all dead. But after running chemical analyses, Wolf and his colleagues realized the cells had died from an altogether different reason than before: They had run out of nutrients because they grew too fast. The new bioreactor was, in a sense, too effective.
The bioreactor’s rotating wall eliminated the problematic mechanical forces that had damaged previous cell cultures, creating a constant free fall effect within the media and suspending the cells in a way very similar to microgravity. As the team discovered means of supplying nutrients and oxygen and removing waste at high enough rates to support the cell cultures, they noticed new structures forming within the bioreactor. While standard human cell cultures grown in Petri dishes settle into flat layers thanks to gravity, the NASA bioreactor’s microgravity mimicry produced very different results.
“These were three-dimensional structures that very accurately represented the way human tissue is structured in the body,” says Wolf. The bioreactor performed even better in space, as was later demonstrated by Wolf himself as an astronaut onboard the STS-86 mission to the Mir Space Station.

“When I first put the space-grown tissue samples under the microscope, I was astounded. With many years of experience culturing tissues, I had never seen any so well organized and with such fine structure,” Wolf says. It was another breakthrough moment, he says, similar to when the team first discovered the ability to assemble 3D tissue on Earth using the simulated microgravity of the NASA bioreactor. Wolf, Schwarz, and Trinh won NASA “Inventor of the Year” honors for their innovation.
Partnership
In 1990, Anderson and Schwarz licensed patents for the rotating wall bioreactor technology and founded Synthecon Inc. in Houston, Texas, to commercialize the device. “When they saw what the technology could do, they thought, ‘Wow, we really have a better mousetrap,’” says Bill Anderson, Charles Anderson’s son and current president of the company. Synthecon’s founders saw great potential in the bioreactor not only as a powerful tool for growing healthy cell cultures, but also as an enabler for more effective drug development and production techniques and even entirely new fields of medicine. The problem was waiting for the rest of the medical industry to catch up, explains Anderson. Scientists were satisfied using flasks to culture cells, and drug companies were relying on the resulting two-dimensional cells, unlike any in the human body, to provide them with data for their pharmaceutical compounds. “The technology was 7 to 8 years ahead of its time,” Anderson says. While Synthecon worked to demonstrate the potential of the rotating wall bioreactor, it received significant support from NASA. “We were fortunate in the early days that NASA saw the importance of the technology and formed a grant program around it,” Anderson says. The Agency funded researchers from schools like Harvard University and the Massachusetts Institute of Technology to test the device’s value for what was then a burgeoning medical field—tissue engineering, seeding an artificial matrix with cells that grow into implantable human tissues. Synthecon provided the bioreactors for these studies, and the results—success growing different tissue types, as well as tumor models for testing cancer treatments outside of the body—led to numerous published findings that added relevance to the technology. “It really helped us stay alive when most small businesses don’t get that benefit,” says Anderson.
Benefits
Synthecon has since built a portfolio of patents based on the original NASA bioreactor and improved upon the original technology in a number of ways, creating models inexpensive enough to be disposable, as well as automated versions that can change the growth media without stopping the reactor’s rotation. Now the company’s NASA-developed Rotary Cell Culture Systems (RCCS)—an “R&D 100” award-winning technology— are key tools for medical research being conducted around the globe, and the company, bioreactor technology, and original NASA innovators were all inducted into the Space Technology Hall of Fame in 2011.
“It might have been ahead of its time, but our technology is really filling its shoes quickly,” Anderson says.

Major pharmaceutical companies, Anderson explains, spend significant amounts of money on drug discovery and now want to test candidate compounds on RCCS-grown, 3D cells to get a more accurate sense of a potential drug’s effects. Synthecon is also scaling up the bioreactor technology for the production of recombinant proteins and antibodies. (Recombinant proteins are expressed from cells containing genetically modified DNA; this is the method used to create human insulin and the hepatitis B vaccine among other vaccinations and disease treatments. Synthecon is working with researchers on recombinant protein studies that may yield drugs for diseases like rheumatoid arthritis and lupus.) The company has found that an RCCS can churn out multifold more product than standard systems because it treats cells so gently, meaning the cells expressing the proteins do not spend energy on repair, a major drain on their productivity. A 100-liter RCCS can thus generate the same output as a 1,000-liter standard system.
Another developing area of medical research in which Synthecon’s NASA technology promises to be a major contributor is regenerative medicine. Much has been made in recent years about the prospects of stem cells to treat conditions as varied as cancer, diabetes, and sickle cell anemia. (In simple terms, stem cells are special cells that can transform into other cell types, offering the potential to replace damaged or malfunctioning cells with healthy ones.) A major obstacle, however, is supply. Synthecon is currently engaged in studies using its RCCS devices to multiply stem cells from umbilical cord blood—a plentiful source without the ethical concerns raised by embryonic stem cells. Cord blood transplants have already been demonstrated to treat leukemia and other cancers, Anderson says, and the RCCS offers the means to efficiently generate the amounts of healthy stem cells necessary for medical use.
Synthecon is also helping improve a therapy technique for Type 1 diabetes. In the pancreas, tiny clusters called islets of Langerhans—each about the size of a period—contain certain cells that generate insulin. Previous methods of transplanting healthy donor islets into a diabetic’s pancreas involved placing the islets into a flask before transplantation, resulting in a roughly 50 percent or worse survival rate for the donor cells, Anderson explains. Researchers working with Synthecon’s technology found that placing the cells in the bioreactor prior to transplantation significantly improved the health of the donor islets, to the point where only one-third as many were needed to produce a secure therapeutic dose. Synthecon is collaborating with the University of Illinois at Chicago Transplant Center to conduct a human clinical trial in 2011.
“We think the bioreactor is going to provide a lot of benefit to a lot of patients moving forward,” says Anderson. “The applications seem to grow every year.”
“I think it is reasonable to say that the fields of regenerative medicine and molecular biology have evolved in the interim years to complement this technology,” says Wolf, who says he is proud to see a technology conceived within the government make a successful transfer to the private sector. “We have a very powerful set of tools to make the next set of innovations and contributions to future medical science.”
Wolf believes that the lunchtime epiphany that led to the development of the NASA bioreactor is indicative of how true innovation works.
“Innovation is an inherently messy process,” he says. “It’s based on the correct balance of sticking to the original plan but also being able to appropriately deviate and adapt to new information and discoveries. The future of NASA, our country, and world is depending on this process for ever more innovations for deep space exploration and for improving life on Earth.”
Rotary Cell Culture System™ and RCCS™ are trademarks of Synthecon Inc.

